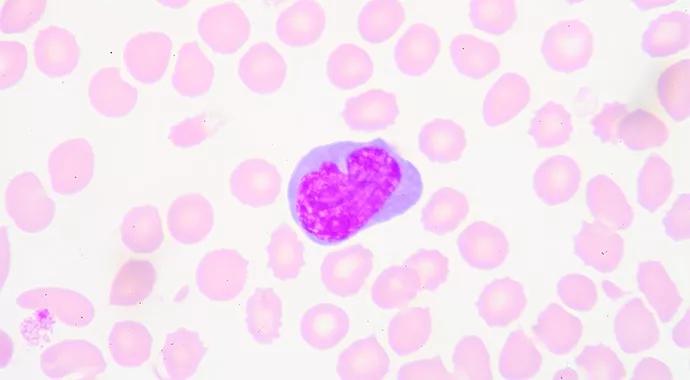

Dysregulation may underlie the varying mood phases
Image content: This image is available to view online.
View image online (https://assets.clevelandclinic.org/transform/655f4622-17ca-46ef-95cc-700ec7dfeaa9/Anand-690x380_jpg)
Anand-690×380
Advertisement
Cleveland Clinic is a non-profit academic medical center. Advertising on our site helps support our mission. We do not endorse non-Cleveland Clinic products or services. Policy
Bipolar disorder is a serious emotional disorder marked by periods of depression and manic and normal (euthymia) moods. Despite decades of research, the biological basis for these changes is still unclear. Changes in brain circuitry oscillations, neurochemical changes and even switching on and off of genes have been proposed.
The latter hypothesis regarding dysregulated genes is particularly intriguing, as bipolar disorder has a strong genetic basis. Moreover, changes of gene expression have been shown to be related to circadian and seasonal rhythms. Therefore, dysregulated gene expression may underlie the mood phases seen in bipolar disorder.
To test this hypothesis, we conducted a study in which genomewide gene expressions were measured in peripheral blood cells for 24 bipolar disorder patients. It has been demonstrated that gene expression in peripheral blood lymphocytes is reasonably well-correlated with expression in the central nervous system.
We collected samples from depressed and manic bipolar patients and analyzed them for RNA (gene expression) using the Affymetrix GeneChip® Human Gene 1.0 ST Array. Gene set enrichment analysis (GSEA) was conducted to identify pathways that are dysregulated in patients. KEGG Pathway and Biological Process Gene Ontology (BP: GO) Pathway (downloaded from the Broad Institute’s Molecular Signatures Database) were additionally used for pathway analysis.
Genomewide gene expression profiles were generated for manic (N = 12) and depressed (N = 12) subjects and resulted in gene expression data for 20,093 genes. Manic and depressed subjects were compared using one-way analysis of variance.
Advertisement
Results for the 10 most significant genes and 10 most significant pathways from GSEA are shown in Tables 1 and 2. In the comparison of gene expression in peripheral lymphocytes between manic and depressive patients, a number of genes had significantly different expression. As seen in Table 1, most of the genes were protein coding, and one involved in signal transduction (phosphoinositide-3-kinase) was among the top 10 significantly different genes.

Image content: This image is available to view online.
View image online (https://assets.clevelandclinic.org/transform/d7f745b9-8788-4616-b879-9b4e7962aa30/Anand-Table1_jpg)
On examination of the functions of these genes from the GeneCards® database and from the data available from the top 10 pathways recognized to be different between mania and depression, it appeared that genes involved in cell division and the cellular cytoskeleton were the most different between the two groups. This is a novel molecular finding regarding differences between the neurobiology of depression and mania.
Another interesting finding was that many of the genes identified were associated with neurological illnesses such as neuropathy, epilepsy and dysautonomia, while others were associated with different types of cancers.

Image content: This image is available to view online.
View image online (https://assets.clevelandclinic.org/transform/e83b8b11-7562-4964-8448-d15453a02181/Anand-Table2_jpg)
At this time, we can only speculate on the implications of these findings. Recent research has shown that cell division is closely linked to circadian rhythms and that molecular mechanisms of circadian rhythms provide information regarding changes in other cellular metabolic processes (Hong et al, 2014).
Hence, genes involved in cell division also may be involved in or influence hormonal or metabolic processes that determine circadian rhythms (Panda et al, 2002). Therefore, the dysregulated genes that relate to cell division will need to be studied in terms of their relationship to circadian rhythms. Gene expression also will need to be measured in the same patients when they switch from one mood to the other to investigate whether the genes identified may be involved in mood switching.
Advertisement
It also has been shown that many cancer cells become autonomous and are not influenced by circadian rhythms, as normal cells are (Fu et al, 2002). The relationship of some of the genes identified in this study to some forms of cancer may therefore be an indicator of disruption of circadian rhythm molecular mechanisms involved in the pathophysiology of bipolar disorder.
Dr. Anand is Vice Chair for Research at Cleveland Clinic’s Center for Behavioral Health and directs the Mood and Emotional Disorders Across the Life Span (MEDALS) program. He is a Professor of Medicine at Cleveland Clinic Lerner College of Medicine.
Advertisement
Advertisement
New study advances understanding of patient-defined goals
Testing options and therapies are expanding for this poorly understood sleep disorder
Real-world claims data and tissue culture studies set the stage for randomized clinical testing
Digital subtraction angiography remains central to assessment of ‘benign’ PMSAH
Cleveland Clinic neuromuscular specialist shares insights on AI in his field and beyond
Findings challenge dogma that microglia are exclusively destructive regardless of location in brain
Neurology is especially well positioned for opportunities to enhance clinical care and medical training
New review distills insights from studies over the past decade